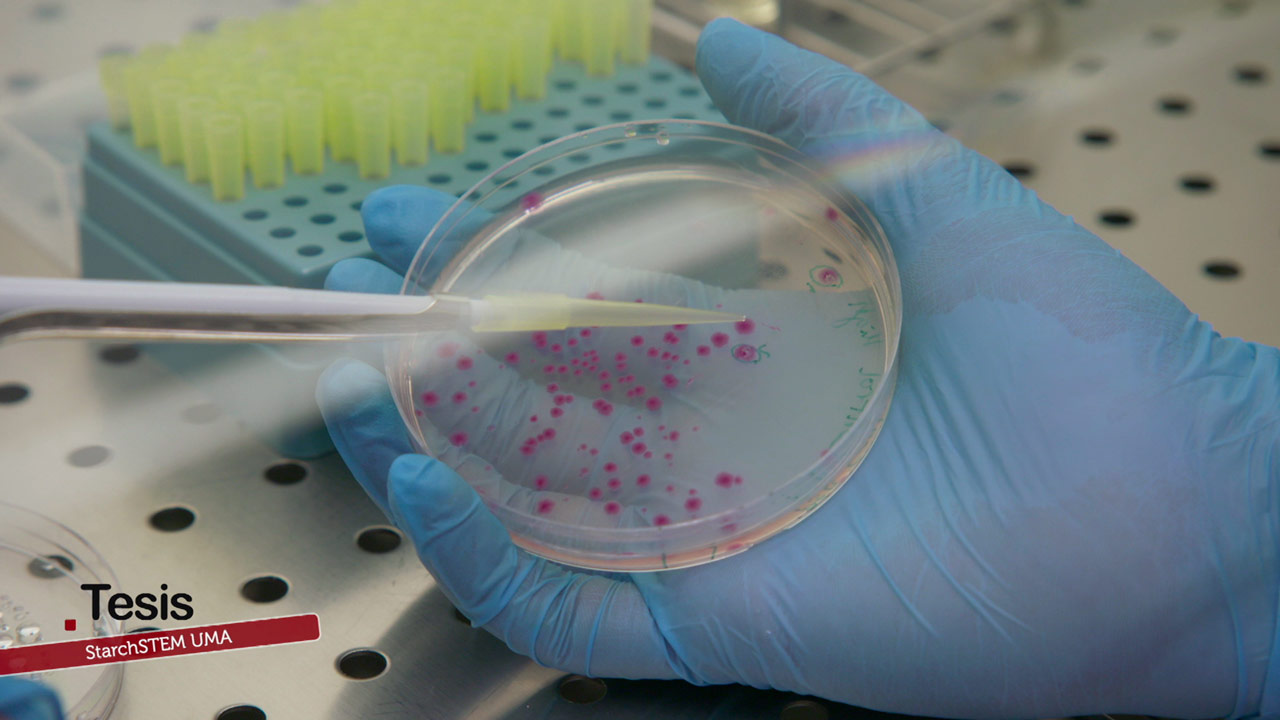

StarchSTEM: El reto de la investigación
StarchSTEM, de iGEM UMA, vuelve por segundo año consecutivo, a trabajar en un interesante proyecto para fomentar la sostenibilidad medioambiental y la economía circular, aunando a investigadores de la Universidad de Málaga con jóvenes estudiantes de diversos grados. En esta ocasión se centran en la modificación genética de la bacteria E. coli, para que sea capaz de degradar la celulosa que se encuentra presente en residuos vegetales como ramas u hojas. Esto permite generar almidón, el cual se podrá utilizar para la elaboración de piensos, bioplásticos o biocombustibles. Además, se trata de un trabajo con proyección más allá de Andalucía, puesto que van a representar a la comunidad autónoma en el concurso internacional de Biología Sintética iGEM, que tendrá lugar en París.
 Tesis se emite el SÁBADO 1/OCT alrededor de las 20:00 h. en ATV (Andalucía Televisión). Repeticiones en ATV, el DOMINGO 2/OCT a las 2:30 h. y el VIERNES 7/OCT a las 12:30 horas.
Tesis se emite el SÁBADO 1/OCT alrededor de las 20:00 h. en ATV (Andalucía Televisión). Repeticiones en ATV, el DOMINGO 2/OCT a las 2:30 h. y el VIERNES 7/OCT a las 12:30 horas.
